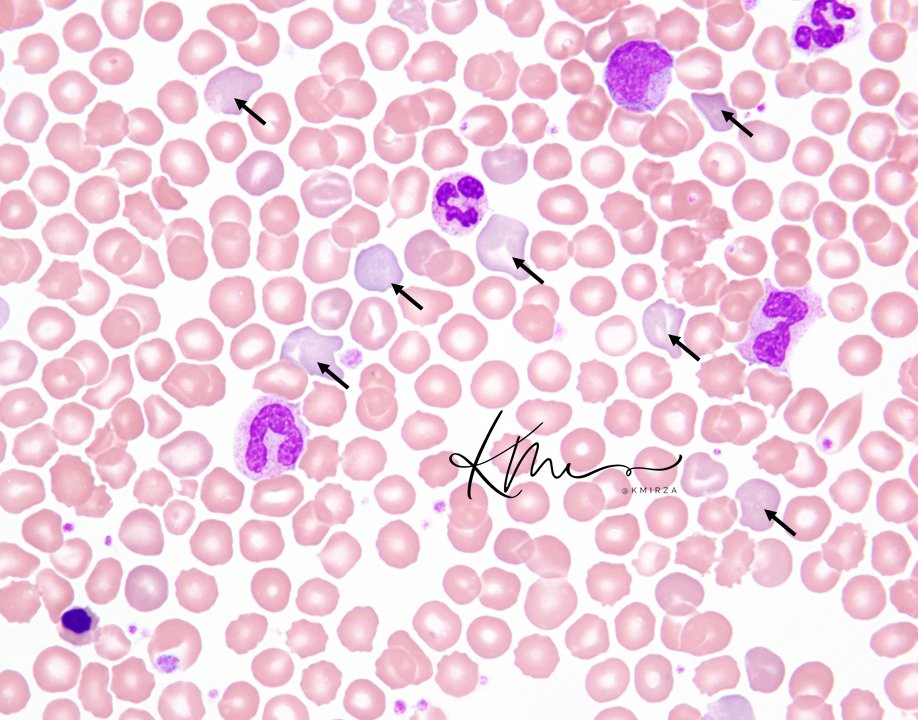
Ever wondered why #reticulocytes are blue-gray on the Wright smear? Residual RNA in the cytoplasm causes this color! Referred to as polychromatophilic red cells, they are 'closer' to having had a nucleus and residual RNA (which stains blue!) #DailyHemepath #leusm #pathology

Julie Huynh
@julie__huynh
MS Medical Laboratory Science Program Assistant at Loyola University | @MLSatLoyola
ID: 1207666749572833281
19-12-2019 14:19:37
67 Tweet
130 Followers
50 Following

What a beautiful day for a graduation! So proud of the (MS) MLS Program Loyola University Chicago Class of 2022! Welcome the profession-I know you will do great things! Kamran Mirza MD PhD - کامران مرزا #Lab4Life #WeSaveLivesEveryday ASCP ASCLS-IL ASCLS



Kristen Pesavento (MS) MLS Program Loyola University Chicago ASCP ASCLS-IL ASCLS Missing Julie Huynh in this picture - she was busy making sure the events run smoothly! Thank you, Julie!



Please join us in congratulating Kristen Pesavento as she becomes our new MLS Program Director and Kamran Mirza MD PhD - کامران مرزا as he becomes our Medical Director! 👏👏👏 Thank you both for all that you do for the MLS program! 🎉🥳



Day 3 of #ASCP2022! Today we have 2 faculty members, Kamran Mirza MD PhD - کامران مرزا and Amanda T. Harrington, PhD, D(ABMM) presenting at the same time on very important topics surrounding leadership and microbiology! #ASCP100







In preparation for Medical Laboratory Professionals Week #MLPW 2023, please vote for Loyola Pathology & Laboratory Medicine's "Saved By The Lab" video by the incredible @SDumaraog! A VERY special video in which ALL arms of healthcare tell us how they were Saved By The Lab! woobox.com/yg54mv/gallery…



Thank you to everyone who showed up and donated blood during our #MLPW2023 sponsored blood drive! 🎈 We reached our goal of collecting 40 units of blood and even got to engage in a fun game with the amazing donors! 🅰️🅱️🆎🅾️🩸 #GiveBloodGiveLife American Red Cross #Lab4Life



Congratulations Julie Huynh! You are incredible and I can’t wait to see all the greatness you will continue to achieve!!!